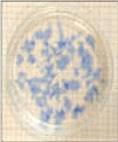

SURFACE TREATIMENT
표면처리
YMT
- information
- Overview
- Key Products
- Facilities

Since establishment in 1999, YMT has grown to
Korea’s representative chemical materials maker
through continued efforts for technological
development to compete with the global toptier companies in the Korean and Chinese
electronic and chemical materials markets
previously dominated by Germany, Japan,
and the U.S. Independently developing and
distributing chemical materials that are essential
in PCB and semiconductor manufacturing
processes, YMT has won recognition of the
value of its products in mobile, electrical vehicle,
and bio fields, and thus is leading the global
chemical materials market.
[information]
- Address
- 30, Namdongdong-ro 153-beongil, Namdong-gu, Incheon Metropolitan City, Korea
- Tel
- +82-32-821-8277
- Fax
- +82-32-821-8271
- Website
- http://www.ymtechnology.com/
Products
PCB final surface treatment, chemical materials for electronic products, such as copper plating
Certifications
ISO9001, ISO14001, Venture Company, Parts and Materials Specialist, INNOBIZ, Incheon Vision Enterprise
Production Facilities
[History]
- 1999 Yuil Material Technology Co., Ltd. established
- 2004 Opened affiliated research center
- 2006 Changed company name to YMT Co., Ltd. Designated as Export Promising Small Enterprise
- 2007 Established subsidiary specializing in PCB plating
- 2012 Won Five-million-dollar Tower of Export Established branch in Taiwan Established branch in China
- 2015 Established branch in Vietnam
- 2017 Listed stocks in KOSDAQ
- 2020 Commenced construction of plant in Zhuhai, China
- information
- Overview
- Key Products
- Facilities
[Business Overview and Key Products]
1) Final Surface Treatment: The final process for PCB and semiconductor electronic materials, which are mainly chemical
materials plated with precious metal, such as gold, silver, and palladium
2) Copper Plating: Chemical material processing to enable electrical connection between layers through copper plating of
drilled holes
3) Process and Display: Chemical material processing for PCB and electronic part production, a wide range of products
available from dry film de-lamination agent to flux cleaning agent
4) Electronic Materials: Ultra thin copper foil manufactured as the first in the world using electroless chemical copper
technique applied to various fields, such as EMI shield, FCCL, and thermal conducting film
5) Semiconductor: Optimal chemical solution customized to customers’ needs for micro-processing
[Features and Strengths]
- B2C business
1) The 100% Cu metal fiber with no nickel or lead content has been independently developed by YMT. It produces far
superior performance to that of the antibacterial materials currently available in the market.
2) YMT plans to release antibacterial mask made with 100% copper fiber in the market. It aims to expand product lineup to
include medical supplies as well as living items with electro-magnetic shield function to protect vulnerable users, such as
infants and pregnant women.
- information
- Overview
- Key Products
- Facilities
[Key Products]
-
 Final Surface Treatment
Final Surface Treatment
-
 Final Surface Treatment
Final Surface Treatment
-
 Copper Foil
Copper Foil
-
 Electroless Chemical Copper
Electroless Chemical Copper
-
 Electrolytic Copper
Electrolytic Copper
-
 Semiconductor
Semiconductor
-
De-lamination
De-lamination
-
 Soft Etching
Soft Etching
-
 Gold Recover
Gold Recover
- information
- Overview
- Key Products
- Facilities
[Production Facilities]
-
 Production Facilities
Production Facilities
-
 Production Facilities
Production Facilities
-
 Participation in International Exposition
Participation in International Exposition
-
 Participation in International Exposition
Participation in International Exposition
 Home
Home Category
Category Search
Search PTSC
PTSC
 KOR
KOR

